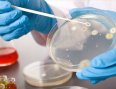

2000 din za PREMIUM PLUS paket briseva i analiza za dame ili muškarce (cervikalni+vaginalni sa antibiogramom/uretralni, klamidija, mycoplazma, ureaplazma, vaginoza, kandida, trihomonas, gonokok)!
Uslovi prodaje
- PONUDA OBUHVATA: 2000 dinara umesto 4650 din. za PREMIUM PLUS paket briseva i analiza za dame ili muškarce (cervikalni+vaginalni sa antibiogramom/uretralni, klamidija, mycoplazma, ureaplazma, vaginoza, kandida, trihomonas, gonokok) -- Labomedica, Bul.Kralja Aleksandra 193/A, Beograd!
- PREMIUM PLUS paket briseva i analiza za dame: cervikalni i vaginalni bris sa antibiogramom, chlamidija, mycoplazma,ureaplazma, vaginoza, kandida, trihomonas,gonokok
- PREMIUM PLUS paket briseva i analiza za muškarce: uretralni bris, chlamydia, mycoplazma, ureaplazma, kandida, trihomonas, gonokok
- Radno vreme: pon-pet 08-19h, subotom 08-13h,
- Obavezno poneti odštampan vaučer sa sobom,
- Obavezno zakazivanje unapred na broj telefona ispisan na vaučeru!
- Rok iskoristivosti vaučera je do 30.12.2020.
2000 din
Redovna cena : 4650 din

Komentari kupaca